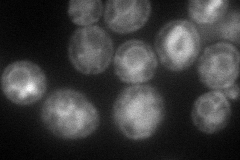
YHR139C
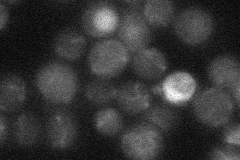
YHR139C

View description
Protein required for spore wall maturation; expressed during sporulation; may be a component of the spore wall; expression also induced in cells treated with the mycotoxin patulin
Localization:
Intensity:
Fold change:
Significance:
-
C’ GFP library in SD

below threshold17.2 -
N' NOP1pr-GFP in SD
ER,vacuole75.8233 -
N' TEF2pr-mCherry in SD

vacuole32.3692 -
N' NATIVEpr-GFP in SD
below threshold18.6881 -
N' TEF2pr-VC and Cyto-VN in SD

#N/A0 -
C’ GFP library in SD+DTT

cytosol17.511.01No -
C’ GFP library in SD+H2O2

cytosol16.710.97No -
C’ GFP library in Starvation Media

cytosol17.531.01No -
C’ GFP library on the background of Pup2-DaMP

below threshold -
C’ GFP library on the background of CCT mutant

below threshold17.25771.00263No
